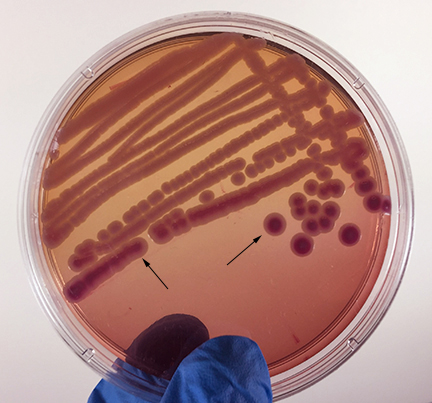

MacConkey agar is a selective medium used for the isolation of non-fastidious Gram-negative rods, particularly members of the family Enterobacteriaceae and the genus Pseudomonas, and the differentiation of lactose fermenting from lactose non-fermenting Gram-negative bacilli. MacConkey agar contains the dye crystal violet well as bile salts that inhibit the growth of most Gram-positive bacteria but do not affect the growth of most Gram-negatives.
Weak fermentation of lactose by the bacteria causes the colonies and confluent growth to appear pink with red centers (arrows), but without the precipitation of bile salts there is no pink halo around the growth.